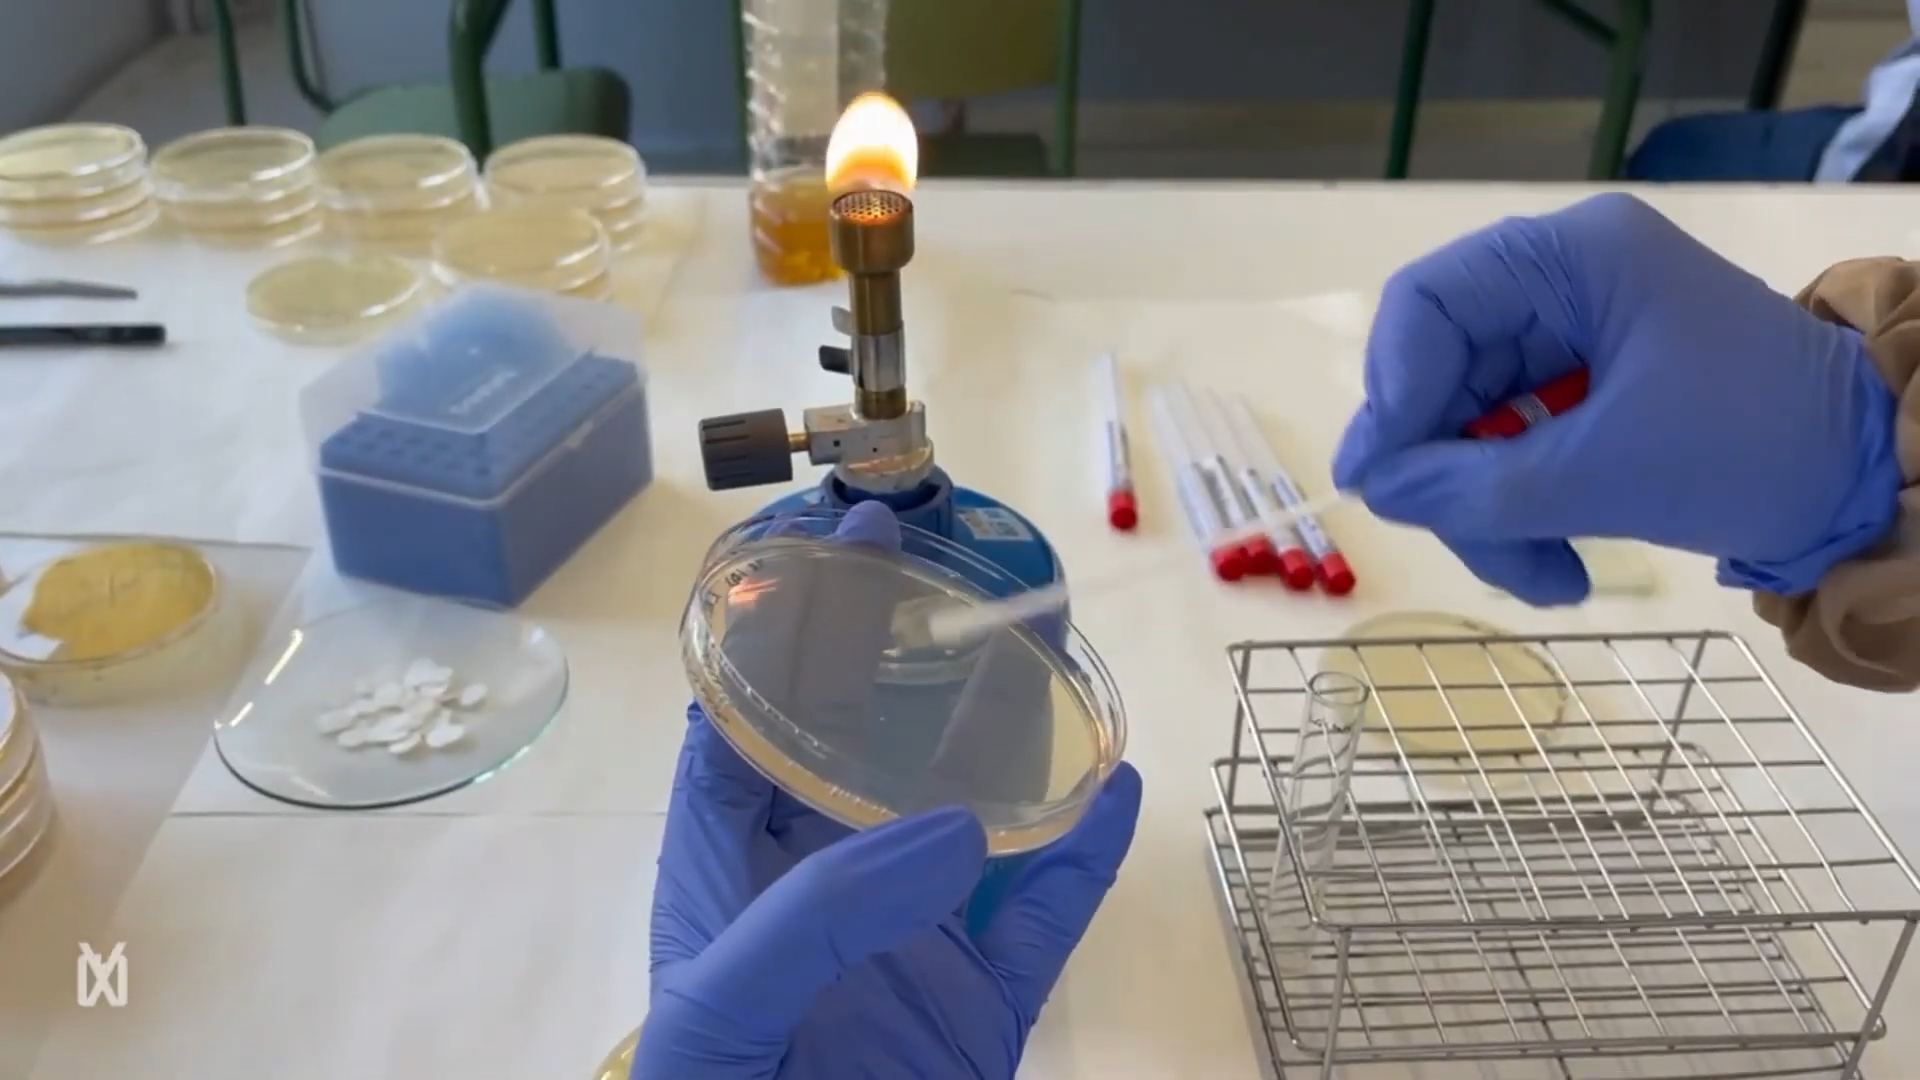
(60) Eix microbiota i salut (Institut de l’Ebre, Tortosa) 00-01-20

Menció X(p)rimenta 2025 en la categoria Batxillerat i Cicles Formatius (Institut de l’Ebre, Tortosa)
Alumnat
- Judit Ginovart
- Alexandra Fernàndez
- Iacma Papaseit Bertomeu
Docent
- Mireia Juan-Camps Castell
Temari curricular
- Projecte de laboratori
Nivell educatiu
- Batxillerat
Objectiu
- Comprovar l’efecte positiu dels probiòtic i prebiòtics i l’efecte negatiu de les pastilles antidepressives sobre la microbiota intestinal.
Material utilitzat
- 1 iogurt natural sense sucres afegits ni additius
- 100 mL d’aigua destil·lada estèril
- Vareta agitadora
- Micropipetes estèrils de 100 µL
- Puntes de micropipeta 3 placa amb medi de cultiu MRS Agar o Agar nutritiu com a alternativa Nansa Digralsky
- Retoladors permanents
- Bec Bunsen
- Incubadora amb temperatura a 37 °C
- Guants i bata de laboratori
- Nanses de sembra d’un sòl ús
- Paper de filtre E.coli com a simulador de microbiota intestinal
- 1 pastilla antidepressiva
Protocol per avaluar l’efecte positiu dels lactobacillus en la microbiota intestinal model in vitro
- Preparem una solució de Lactobacillus a partir d’una colònia per cada 1 mL de solució salina estèril.
- Sembrar amb una criobola Escherichia coli amb sembra gespa en agar Mueller-Hinton.
- Impregnar quatre discs de paper de filtre amb la solució de Lactobacillus i els col·loquem a cada quadrant de la placa de medi d’agar Mueller-Hinton amb l’Escherichia coli prèviament inoculat.
- Incubem a 37 °C durant 24 hores. Observem els resultats.
Protocol per avaluar l’efecte positiu dels prebiòtics naturals en la microbiota intestinal model in vitro
- Sembrem Escherichia coli cultiu pur, jove i fresc amb sembra gespa en agar Mueller-Hinton.
- Impregnem quatre discs de paper de filtre amb la dissolució anterior i els col·loquem a cada quadrant de la placa d’agar Mueller-Hinton amb l’Escherichia coli prèviament inoculat.
- Incubem a 37 °C durant 24 hores.
Protocol de l’efecte dels antidepressius sobre la microbiota intestinal
- Sembrem Escherichia coli cultiu pur, jove i fresc amb sembra gespa en agar Mueller-Hinton.
- Dissolem la pastilla antidepressiva i fem dilucions seriades, calculades amb anterioritat Solució inicial 5 ml d’aigua destil·lada 50 g de pastilla nom: concentració 50 mg / 5 mL 10 mg/mL 1a dilució 5 ml d’aigua destil·lada 1 ml de la solució anterior; concentració 1 mL 10 mg/mL/ 5 mL 2 mg/mL 2a dilució 5 ml d’aigua destil·lada 1 ml de la solució anterior; concentració 1 mL 2 mg/mL/ 5 mL 0,4 mg/mL 3a dilució 5 ml d’aigua destil·lada 1 ml de la solució anterior; concentració 1 mL 0,4 mg/mL / 5 mL 0,08 mg/mL
- Apliquem petites gotes de cada dilució diferents concentracions de l’antidepressiu amb aigua destil·lada en discs de paper de filtre.
- Afegim els discos de paper, segons la seva concentració, en cada quadrant de la placa d’agar Mueller-Hinton amb l’Escherichia coli prèviament inoculat.
- Incubem a 37 °C durant 24 hores i observem els resultats.
Si voleu reproduir aquest experiment, heu de comptar sempre amb la supervisió d’un adult.

0 Comentaris